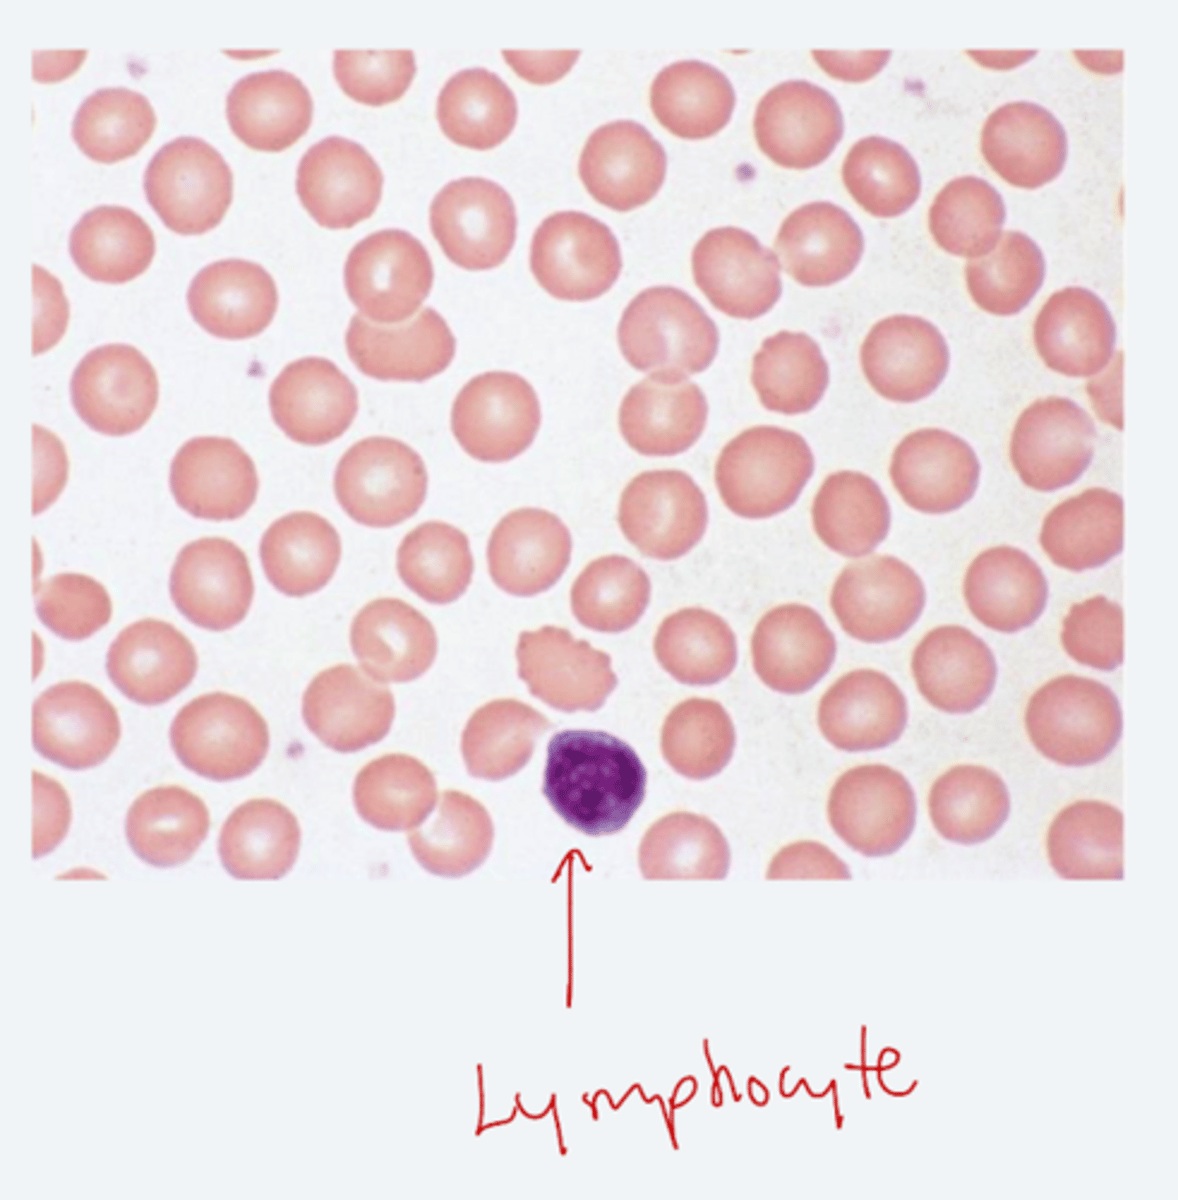
<p>1. same size as lymphocyte nucleus</p><p>2. central pallow = 1/3 cell diameter</p>
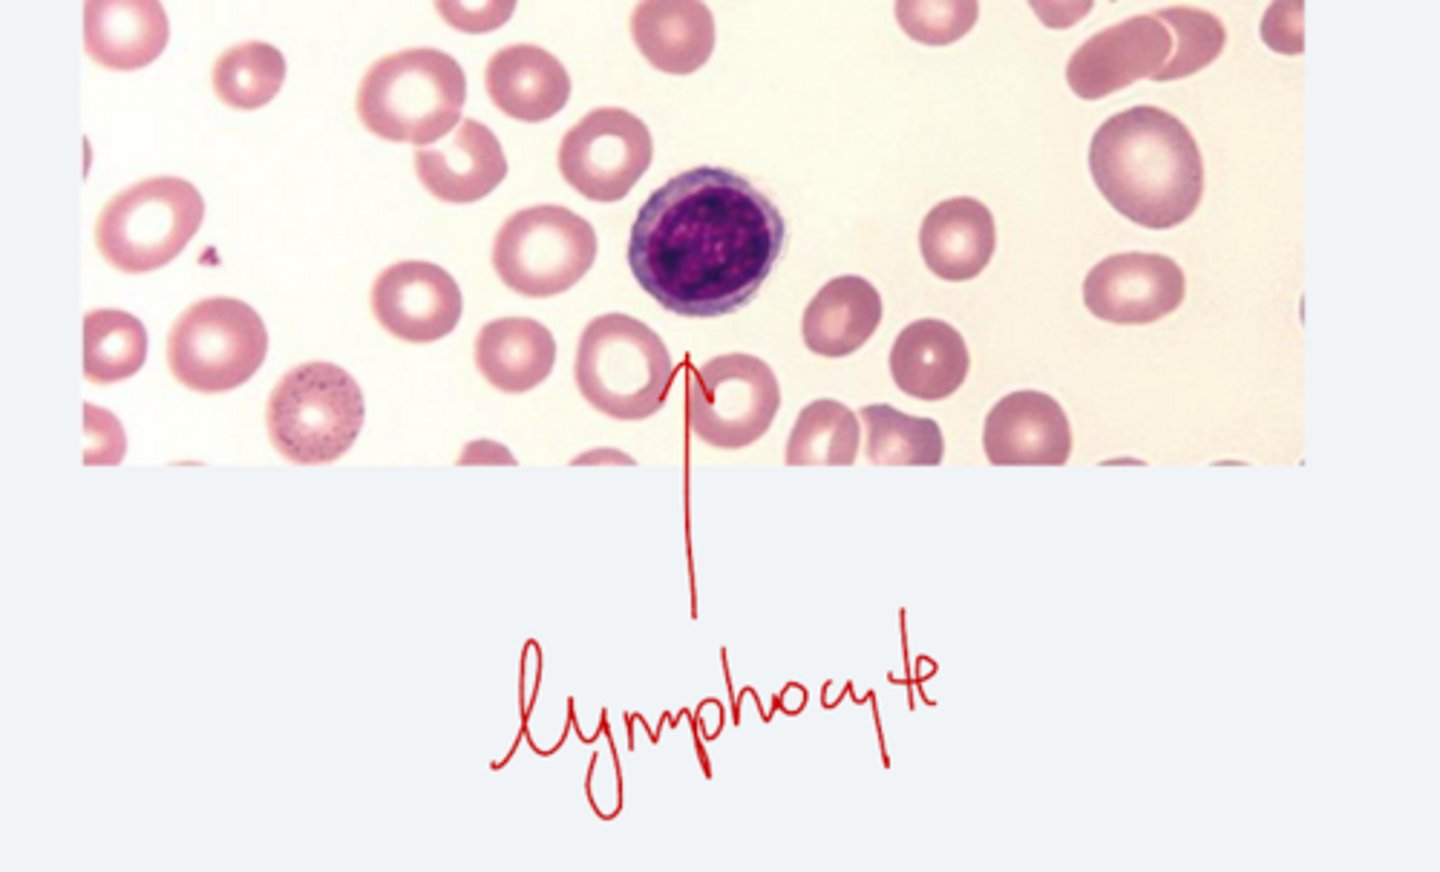
<p>1. smaller size as a lymphocyte nucleus</p><p>2. central pallow = > 1/3 cell diameter</p><p>3. cause: iron deficiency</p>
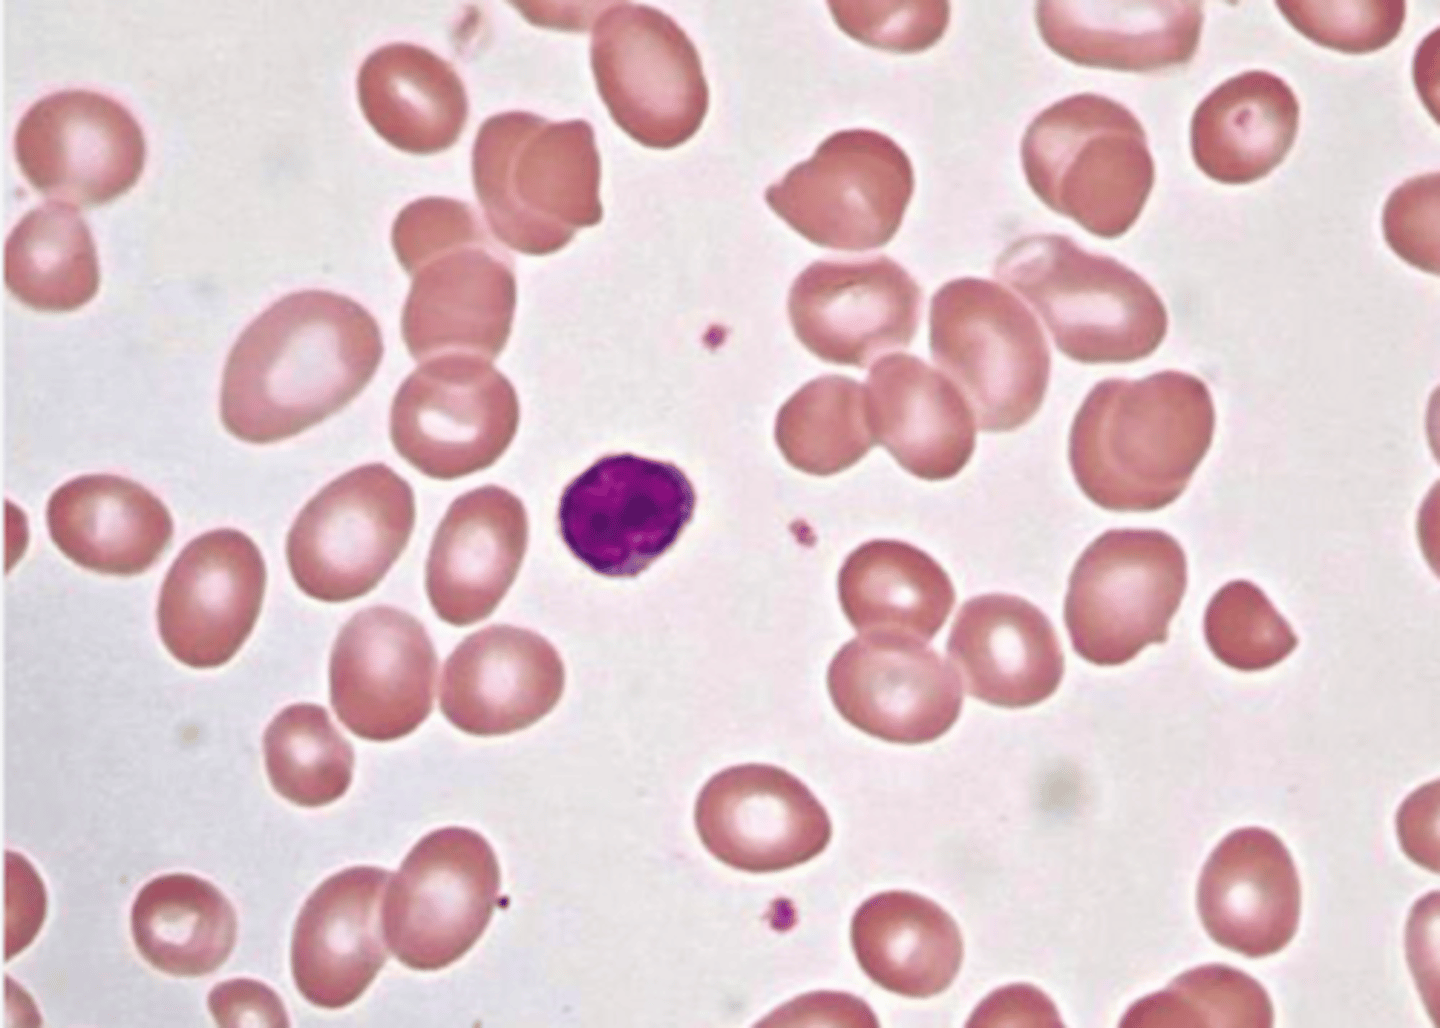
<p>1. bigger size than a lymphocyte nucleus</p><p>2. central pallow = < 1/3 cell diameter</p><p>3. cause: B12/folate deficiency</p>
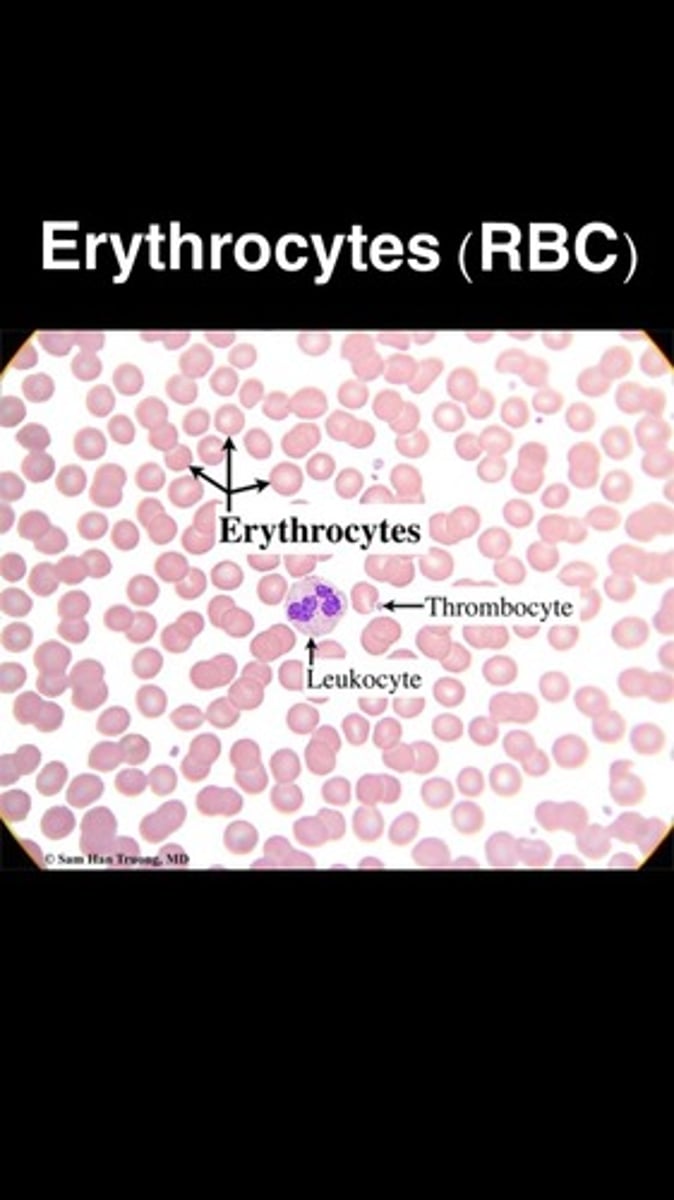
<p>biconcave shape</p><p>- size: 7-8uM</p><p>- MCV: 80-100fL</p>
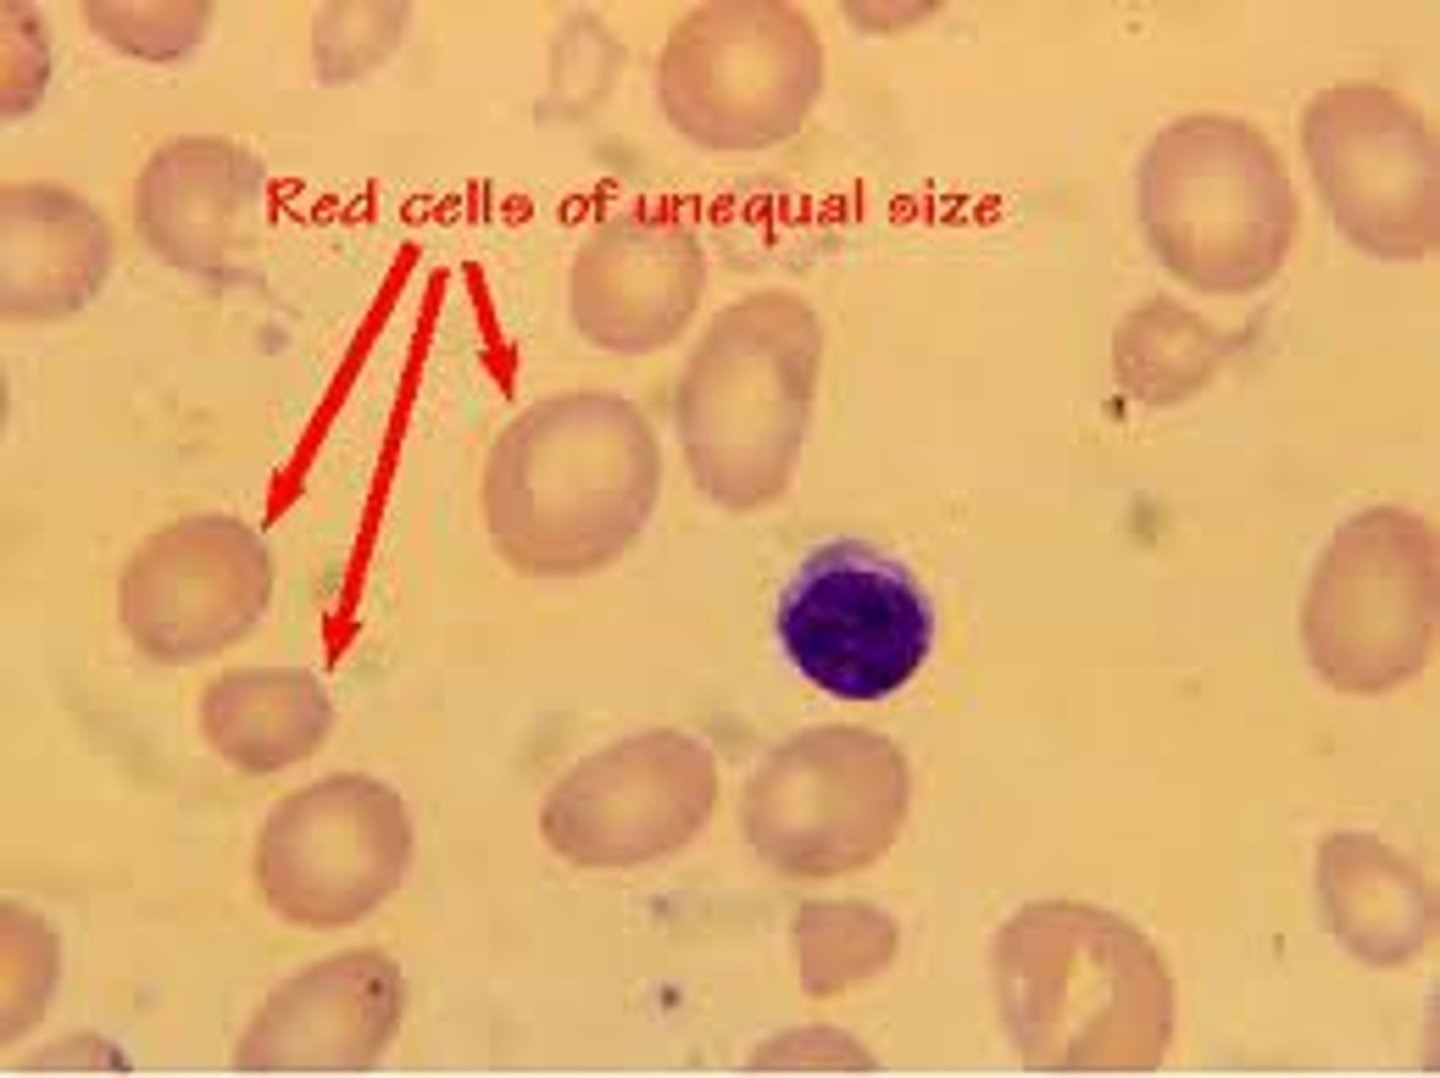
<p>variation in red cell size</p>

Module 3 - Topic 1 - Part 1 & 2 - Complete Blood Count
1/164
There's no tags or description
Looks like no tags are added yet.
Name | Mastery | Learn | Test | Matching | Spaced | Call with Kai |
|---|
No analytics yet
Send a link to your students to track their progress
165 Terms
The purpose of CBC is to identify:
1. anemias
2. infection
3. bleeding disorders
CBC
complete blood count
- lab test that quantifies blood cells and associated indices

Key components of CBC
1. RBCs
2. WBCs
3. Platelets
4. hgb/hct

hgb
hemoglobin
Hct
hematocrit
Why do we order a CBC?
1. detect abnormalities
2. diagnosis and treatment
3. health evaluation
4. Rule out disease
5. monitoring
What protein do eosinophils produce?
MBP
What protein do neutrophils produce?
MPO
What protein do basophils produce?
histamine and heparin
RBCs =
is there anemia?
RBC interpretation includes;
1. hgb
2. hct
3. RBC count
decrease in RBCs
anemia
increase in RBCs
polycythemia
RBC indices =
what type of anemia?
RBC indices include;
1. MCV
2. MCHC
3. RDW
MCV
size (micro/normo/macro)
MCHC
color (hypo/normochromic)
RDW
variation in size
- compare to lymphocyte

WBCs =
infection or inflammation?
WBCs indices include;
total WBC count
- neutrophil
- lymphocytes
- eosinophils
neutrophils
bacterial
lymphocytes
viral
eosinophils
allergy/parasites
platelets indices =
bleeding or clotting risk?
platelet indices include;
platelet count
decrease in platelets
bleeding risk
increase in platelets
clotting risk
RBC count;
number of circulating red blood cells
hemoglobin (Hgb)
oxygen-carrying protein in RBCs
Hematocrit (Hct)
percentage of blood volume occupied by RBCs
WBC count and differential
types of white blood cells and their proportions
platelet count
important for clotting and bleeding disorders
mean platelet volume (MPV)
reflects platelet size and production activity
WBC reported as
10^3 /uL
RBC reported as
10^6/uL
Hct is expressed as
a percentage %
Hct % =
(MCV x RBC) / 10
Hct is
the proportion of blood volume composed of RBCs
Rule of three
1. RBC count x 3 = Hgb
2. Hgb x 3 = Hct %
3. RBC count x 9 = Hct %

rule of three acceptable variance
+/- 3
The rule of three is important in identifying
anemias
MCV
size
MCHC =
concentration / color
MCH =
amount
Hgb give RBCs their
color
MCV measures
Avg RBC size
- microcytic vs macrocytic

MCH measures
Avg Hgb per RBC
- general hemoglobin content

MCHC measures
Hgb concentration
- normochromic vs hypochromic

RDW measures
variation in RBC size
- detects anisocytosis

MCV
mean cell volume
reference interval MCV
80-100 fL
MCV is the most important RBC index in the
initial diagnosis of anemia
increase in MCV =
cells appear large (macrocytic)
decrease in MCV =
cells appear smaller (microcytic)
deviations from normal MCV guides differential diagnosis of
anemia subtypes
microcytic anemia
iron deficiency
macrocytic anemia
B12/folate deficiency
MCH
mean cell hemoglobin
MCH equation =
(Hgb)(10) / RBC

MCH does not reflect
hemoglobin concentration, only total hemoglobin per cell
MCH reference range
27-33 pg
MCHC
mean cell hemoglobin concentration
MCHC equation =
(Hgb)(100) / Hct %

MCHC tells us if RBC is
normochromic or hypochromic
Hypochromic central pallor
> 1/3
hyperchromic central pallor
< 1/3
can ONLY tell the size of an RBC if there is a reference
lymphocyte
hyperchromic is
very uncommon
reference range for MCHC
32-36 g/dL
normocytic, normochromic RBCs
1. same size as lymphocyte nucleus
2. central pallow = 1/3 cell diameter
microcytic, hypochromic RBCs
1. smaller size as a lymphocyte nucleus
2. central pallow = > 1/3 cell diameter
3. cause: iron deficiency
macrocytic RBCs
1. bigger size than a lymphocyte nucleus
2. central pallow = < 1/3 cell diameter
3. cause: B12/folate deficiency
RDW
RBC distribution width
RDW measures
variation in RBC size (anisocytosis)
high RDW indicates
increase in size variability
RDW is useful in distinguishing between
anemias
reference interval range RDW
11.5-14.5%
normal RDW with low MCV =
thalassemia trait
high RDW with low MCV =
iron deficiency
reticulocytes
immature RBCs
reticulocytes contains
residual organelles, including ribosomes for hemoglobin synthesis
normal reticulocyte count in peripheral blood
<3%
>3% reticulocytes in peripheral blood indicates
increase in RBC production
what is one of the most useful test for anemia monitoring
reticulocyte count
what stain is used in reticulocyte count
super vital stain
- stains RNA
super vital stain includes;
1. methylene blue
2. brilliant cresyl blue
MPV
mean platelet volume
increase in MPV =
increase in RBC production
decrease in MPV =
decrease in RBC production
WBC differential
analysis and enumeration of various WBC subtypes
- manual or automated
blood smears are stained with
wright's stain
romanowsky-type stain is the same as a
wright's stain
Wright's stain
a special dye used to stain blood smears so you can see and identify different blood cells under a microscope
Erythrocyte (RBC)
biconcave shape
- size: 7-8uM
- MCV: 80-100fL
central pallor
the central pale area of an RBC that represents the thinnest part of the biconcave disc
- 1/3 of the cell diameter
Anisocytosis
variation in red cell size
Anisocytosis detects;
1. blood smear
2. RDW and MCV
RDW
variation in RBC size (not avg size)
MCV
avg RBC size
Anisocytosis classification
1. macrocytic = larger than normal
2. microcytic = smaller than normal